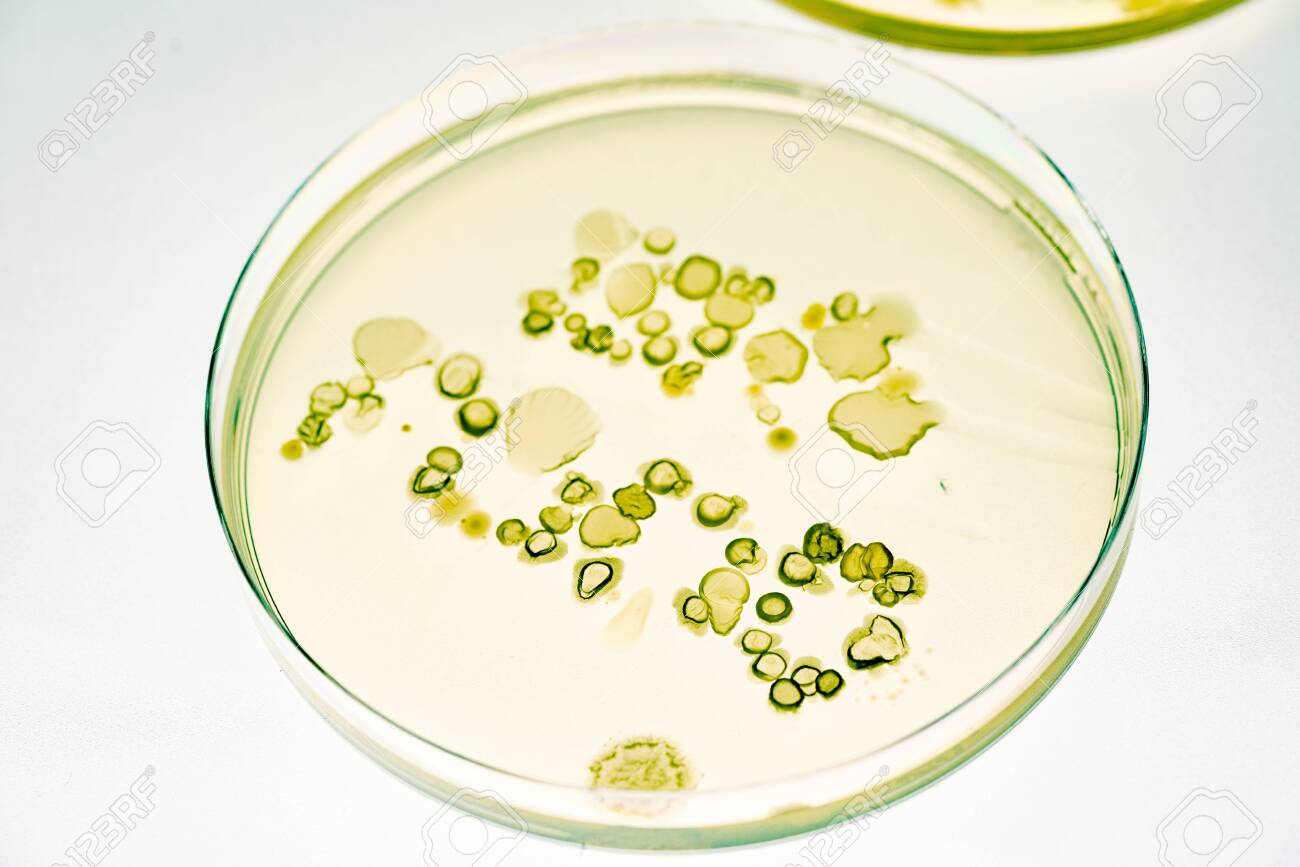
Growing Bacteria In Petri Dishes On Agar Gel Scientific Experiment Stock Photo Picture And Royalty Free Image Image 141030914

Growing bacteria in petri dishes with agar
Growing Bacteria In Petri Dishes With Agar. I purchased a set of petri dishes that were pre filled with agar a substance that bacteria like to feed on. If aseptic technique is not used bacteria from the environment will be introduced to the media and the media will become contaminated and useless. Bacteria are microorganisms that grow everywhere. First prepare your agar by swirling it and then pouring it into an open petri dish.
 Growing Bacteria In Petri Dishes On Agar Gel Scientific Experiment Stock Photo Alamy From alamy.com
Growing Bacteria In Petri Dishes On Agar Gel Scientific Experiment Stock Photo Alamy From alamy.com
Lift the lid off the petri dish and lightly draw a squiggly line in the agar with the end of the cotton swab. There are glass and plastic petri dishes and both can be sterilized using an autoclave and re used. I purchased a set of petri dishes that were pre filled with agar a substance that bacteria like to feed on. After this swab it onto the petri dish and let it sit for around a week. Next close the cap to the petri dish and let it sit for an hour. Before being used for culture purposes it is important to ensure that the petri dish is not only clean but also.
Roll the swab in your fingers as you draw the line.
A petri dish petri plate is a shallow cylindrical glass lidded dish that is typically used to culture microorganisms agar plates. We labeled the bottom of our petri dish with the items we planned to culture. Roll the swab in your fingers as you draw the line. Replace the lid and label the dish with the date and the name of the item you tested. Lift the lid off the petri dish and lightly draw a squiggly line in the agar with the end of the cotton swab. We can collect and grow them in specially prepared petri dishes.
 Source: giftofcuriosity.com
Source: giftofcuriosity.com
First prepare your agar by swirling it and then pouring it into an open petri dish. Place the mixture in the microwave for 1 minute until the water boils and then let it cool to room temperature before pouring the mixture into the dish. We labeled the bottom of our petri dish with the items we planned to culture. If you want to grow bacteria in a petri dish prepare an agar by mixing 1 2 teaspoon of agar powder with 1 4 cup of water. We can collect and grow them in specially prepared petri dishes.
 Source: 123rf.com
Source: 123rf.com
We can collect and grow them in specially prepared petri dishes. Place the mixture in the microwave for 1 minute until the water boils and then let it cool to room temperature before pouring the mixture into the dish. A petri dish is a round shallow clear colored dish with a lid used to culture microorganisms such as bacteria. Blood agar or tryptic soy agar with 5 sheep s blood is an excellent medium for supplying bacteria with nutrients and an environment in which we can see them grow. Next close the cap to the petri dish and let it sit for an hour.
 Source: pinterest.com
Source: pinterest.com
I purchased a set of petri dishes that were pre filled with agar a substance that bacteria like to feed on. Bacteria are microorganisms that grow everywhere. Replace the lid and label the dish with the date and the name of the item you tested. A petri dish petri plate is a shallow cylindrical glass lidded dish that is typically used to culture microorganisms agar plates. Blood agar or tryptic soy agar with 5 sheep s blood is an excellent medium for supplying bacteria with nutrients and an environment in which we can see them grow.
 Source: stevespanglerscience.com
Source: stevespanglerscience.com
Agar is often ultimately poured into sterile petri dishes plates. A petri dish is a round shallow clear colored dish with a lid used to culture microorganisms such as bacteria. After this swab it onto the petri dish and let it sit for around a week. Before being used for culture purposes it is important to ensure that the petri dish is not only clean but also. I purchased a set of petri dishes that were pre filled with agar a substance that bacteria like to feed on.
Source: 123rf.com
Source: 123rf.com
Place the mixture in the microwave for 1 minute until the water boils and then let it cool to room temperature before pouring the mixture into the dish. We can collect and grow them in specially prepared petri dishes. We labeled the bottom of our petri dish with the items we planned to culture. A petri dish is a round shallow clear colored dish with a lid used to culture microorganisms such as bacteria. Next close the cap to the petri dish and let it sit for an hour.

Next grab a q tip and swab it on a surface you prefer. First prepare your agar by swirling it and then pouring it into an open petri dish. I purchased a set of petri dishes that were pre filled with agar a substance that bacteria like to feed on. If you want to grow bacteria in a petri dish prepare an agar by mixing 1 2 teaspoon of agar powder with 1 4 cup of water. Place the mixture in the microwave for 1 minute until the water boils and then let it cool to room temperature before pouring the mixture into the dish.
 Source: sciencebob.com
Source: sciencebob.com
After this swab it onto the petri dish and let it sit for around a week. If aseptic technique is not used bacteria from the environment will be introduced to the media and the media will become contaminated and useless. Next close the cap to the petri dish and let it sit for an hour. Replace the lid and label the dish with the date and the name of the item you tested. Moisture coming from the agar can be a problem.
 Source: m.youtube.com
Source: m.youtube.com
Roll the swab in your fingers as you draw the line. A petri dish petri plate is a shallow cylindrical glass lidded dish that is typically used to culture microorganisms agar plates. Before being used for culture purposes it is important to ensure that the petri dish is not only clean but also. Agar is often ultimately poured into sterile petri dishes plates. In this tutorial we learn how to grow bacteria with agar and petri dishes.
 Source: 123rf.com
Source: 123rf.com
Replace the lid and label the dish with the date and the name of the item you tested. Agar is often ultimately poured into sterile petri dishes plates. We can collect and grow them in specially prepared petri dishes. After this swab it onto the petri dish and let it sit for around a week. Replace the lid and label the dish with the date and the name of the item you tested.
 Source: stevespanglerscience.com
Source: stevespanglerscience.com
First prepare your agar by swirling it and then pouring it into an open petri dish. If you want to grow bacteria in a petri dish prepare an agar by mixing 1 2 teaspoon of agar powder with 1 4 cup of water. First prepare your agar by swirling it and then pouring it into an open petri dish. We can collect and grow them in specially prepared petri dishes. Lift the lid off the petri dish and lightly draw a squiggly line in the agar with the end of the cotton swab.
 Source: m.youtube.com
Source: m.youtube.com
A petri dish petri plate is a shallow cylindrical glass lidded dish that is typically used to culture microorganisms agar plates. After this swab it onto the petri dish and let it sit for around a week. There are glass and plastic petri dishes and both can be sterilized using an autoclave and re used. Before being used for culture purposes it is important to ensure that the petri dish is not only clean but also. We labeled the bottom of our petri dish with the items we planned to culture.
 Source: m.youtube.com
Source: m.youtube.com
After this swab it onto the petri dish and let it sit for around a week. Place the mixture in the microwave for 1 minute until the water boils and then let it cool to room temperature before pouring the mixture into the dish. If you want to grow bacteria in a petri dish prepare an agar by mixing 1 2 teaspoon of agar powder with 1 4 cup of water. In this tutorial we learn how to grow bacteria with agar and petri dishes. A petri dish is a round shallow clear colored dish with a lid used to culture microorganisms such as bacteria.
 Source: alamy.com
Source: alamy.com
Replace the lid and label the dish with the date and the name of the item you tested. A petri dish petri plate is a shallow cylindrical glass lidded dish that is typically used to culture microorganisms agar plates. Roll the swab in your fingers as you draw the line. If you want to grow bacteria in a petri dish prepare an agar by mixing 1 2 teaspoon of agar powder with 1 4 cup of water. I purchased a set of petri dishes that were pre filled with agar a substance that bacteria like to feed on.
 Source: pinterest.com
Source: pinterest.com
Lift the lid off the petri dish and lightly draw a squiggly line in the agar with the end of the cotton swab. Next close the cap to the petri dish and let it sit for an hour. Moisture coming from the agar can be a problem. Agar is often ultimately poured into sterile petri dishes plates. I purchased a set of petri dishes that were pre filled with agar a substance that bacteria like to feed on.
 Source: madaboutscience.com.au
Source: madaboutscience.com.au
Place the mixture in the microwave for 1 minute until the water boils and then let it cool to room temperature before pouring the mixture into the dish. A petri dish is a round shallow clear colored dish with a lid used to culture microorganisms such as bacteria. Agar is often ultimately poured into sterile petri dishes plates. Before being used for culture purposes it is important to ensure that the petri dish is not only clean but also. Roll the swab in your fingers as you draw the line.
If you find this site serviceableness, please support us by sharing this posts to your preference social media accounts like Facebook, Instagram and so on or you can also save this blog page with the title growing bacteria in petri dishes with agar by using Ctrl + D for devices a laptop with a Windows operating system or Command + D for laptops with an Apple operating system. If you use a smartphone, you can also use the drawer menu of the browser you are using. Whether it’s a Windows, Mac, iOS or Android operating system, you will still be able to bookmark this website.




